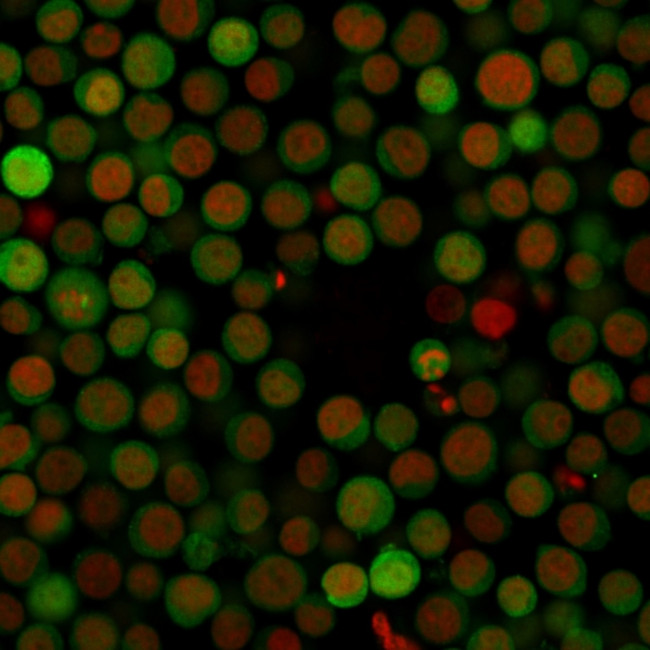
PD-L1/PDCD1LG1/CD274/B7-H1 (Cancer Immunotherapy Target) Antibody in Immunocytochemistry (ICC/IF)

Search
NeoBiotechnologies
PD-L1/PDCD1LG1/CD274/B7-H1 (Cancer Immunotherapy Target) Monoclonal Antibody (PDL1, 2746)
{{$productOrderCtrl.translations['antibody.pdp.commerceCard.promotion.promotions']}}
{{$productOrderCtrl.translations['antibody.pdp.commerceCard.promotion.viewpromo']}}
{{$productOrderCtrl.translations['antibody.pdp.commerceCard.promotion.promocode']}}: {{promo.promoCode}} {{promo.promoTitle}} {{promo.promoDescription}}. {{$productOrderCtrl.translations['antibody.pdp.commerceCard.promotion.learnmore']}}
图: 1 / 10
PD-L1/PDCD1LG1/CD274/B7-H1 (Cancer Immunotherapy Target) Antibody (29126-MSM6-P1) in ICC/IF










产品信息
29126-MSM6-P1
种属反应
宿主/亚型
分类
类型
克隆号
抗原
偶联物
形式
浓度
规格
纯化类型
保存液
内含物
保存条件
运输条件
产品详细信息
Immunohistochemistry (PFA fixed): incubate antibody for 30 min RT. Staining of formalin-fixed tissues requires heating tissue sections in 10mM Tris with 1mM EDTA, pH 9.0, for 45 min at 95 degrees C followed by cooling at RT for 20 minutes.
靶标信息
Programmed death receptor ligand 1 (PD-L1, also called B7-H1) is a recently described B7 family member. To date, one specific receptor has been identified that can be ligated by PD-L1. This receptor, programmed death receptor 1 (PD-1), has been shown to negatively regulate T-cell receptor (TCR) signaling. Upon ligating its receptor, PD-L1 has been reported to decrease TCR-mediated proliferation and cytokine production. PD-L1 expression was found to be abundant on many murine and human cancers and could be further up-regulated upon IFN-gamma stimulation. Thus, PD-L1 might play an important role in tumor immune evasion.
仅用于科研。不用于诊断过程。未经明确授权不得转售。
篇参考文献 (0)
生物信息学
蛋白别名: B7 homolog 1; B7-H1; B7-H1,PD-L1; CD274; CD274 antigen; costimulatory molecule; PD-L1; PDCD1 ligand 1; pdl-1; Programmed cell death 1 ligand 1; programmed death ligand 1; programmed death-1 ligand 1; sCD274; similar to Homo sapiens B7-1 and B7-2; soluble CD274; soluble PD L1; soluble PD-L1; B7-H1; sPD L1; unnamed protein product
基因别名: A530045L16Rik; B7-H; B7H1; CD274; hPD-L1; PD-L1; PDCD1L1; PDCD1LG1; PDL1
UniProt ID: (Human) Q9NZQ7, (Mouse) Q9EP73
Entrez Gene ID: (Human) 29126, (Mouse) 60533